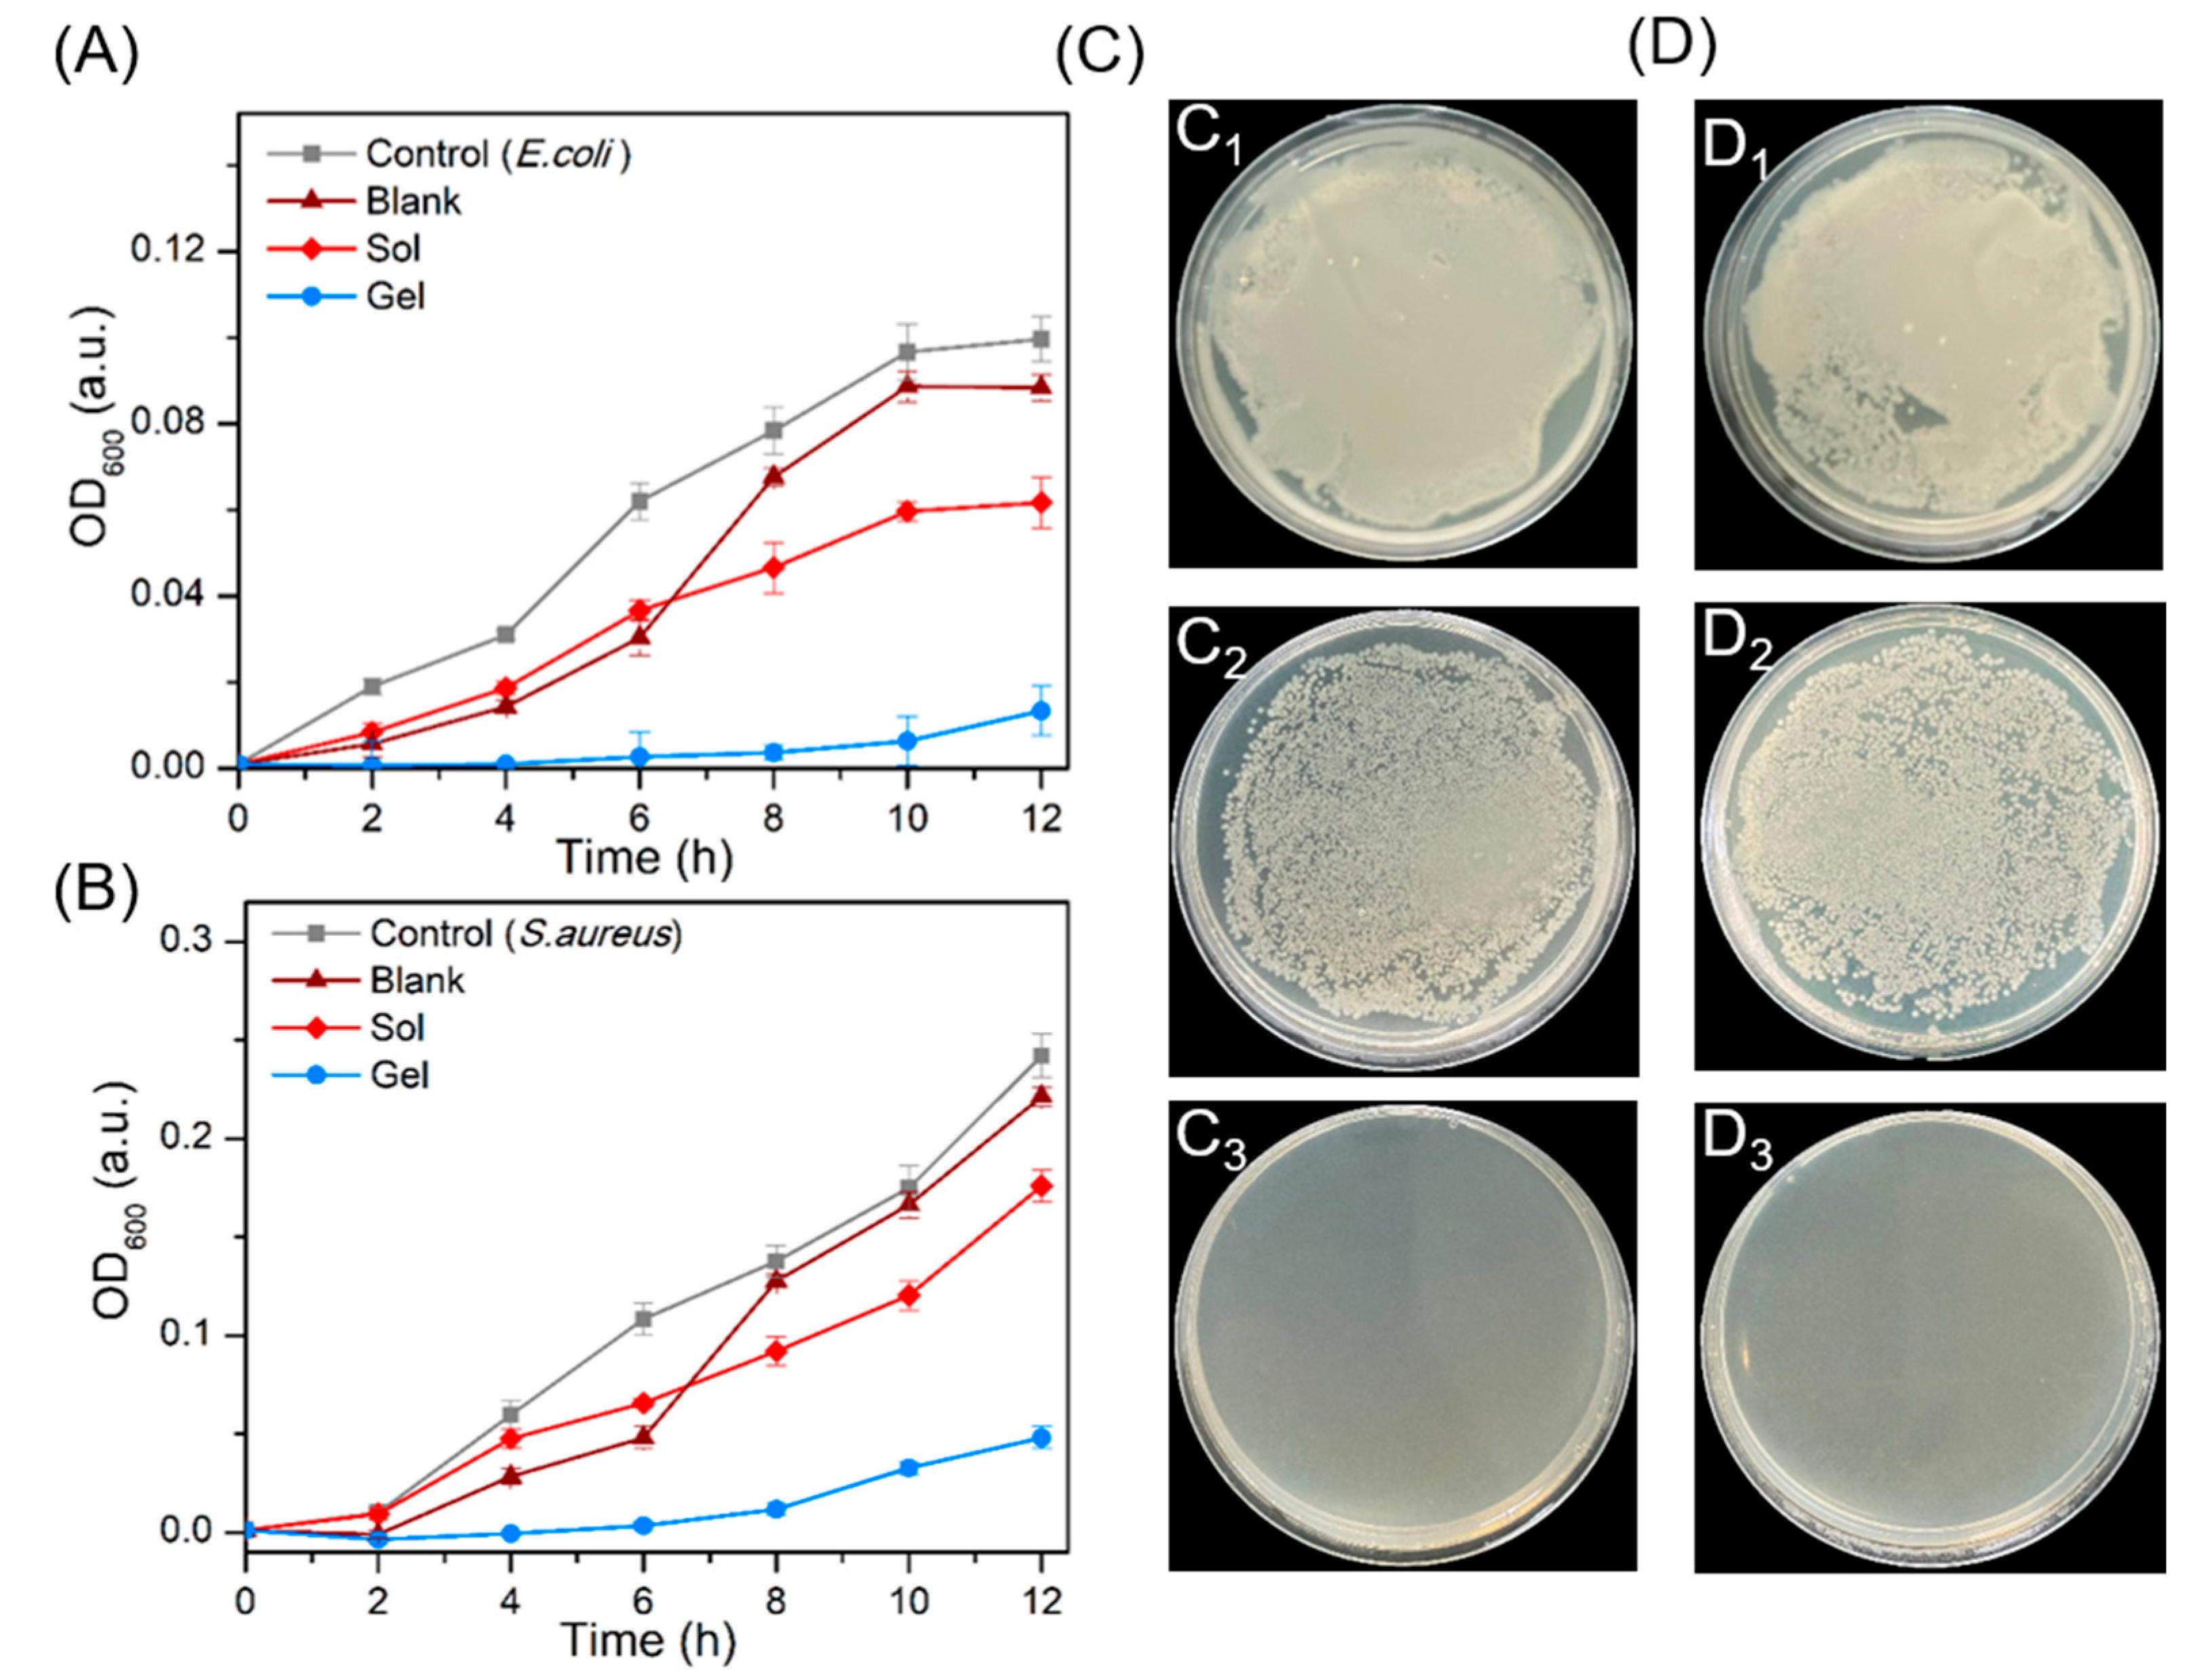
Molecules 28 03334 g005

One-Step Construction of Tryptophan-Derived Small Molecule Hydrogels for Antibacterial Materials
Abstract
1. Introduction
2. Results and Discussion
2.1. Hydrogel Preparation
2.2. Dynamics Simulation
2.3. Self-Assembly Mechanism of Hydrogel
2.4. Drug Release and Cytotoxicity Evaluation
2.5. Antibacterial Properties
3. Materials and Methods
3.1. Materials
3.2. Preparation of Hydrogels
3.3. Characterization
3.4. All-Atom Molecular Dynamics (AAMD)
3.5. Rheological Mechanical
3.6. Sustained Release Test
3.7. Cytotoxicity Assay
3.8. Antimicrobial Activity Studies
4. Conclusions
Supplementary Materials
Author Contributions
Funding
Institutional Review Board Statement
Informed Consent Statement
Data Availability Statement
Acknowledgments
Conflicts of Interest
References
- Hageneder, S.; Jungbluth, V.; Soldo, R.; Petri, C.; Pertiller, M.; Kreivi, M.; Weinhausel, A.; Jonas, U.; Dostalek, J. Responsive hydrogel binding matrix for dual signal amplification in fluorescence affinity biosensors and peptide microarrays. ACS Appl. Mater. Interfaces 2021, 13, 27645–27655. [Google Scholar] [CrossRef] [PubMed]
- Rothe, R.; Xu, Y.; Thomas, A.K.; Meister, S.; Zhang, Y.; Pietzsch, J.; Hauser, S. A modular, injectable, non-covalently assembled hydrogel system features widescale tunable degradability for controlled release and tissue integration. Biomaterials 2021, 269, 120637. [Google Scholar] [CrossRef] [PubMed]
- Aye, S.S.S.; Zhang, Z.H.; Yu, X.; Ma, W.D.; Yang, K.; Yuan, B.; Liu, X.; Li, J.L. Antimicrobial and bioactive silk peptide hybrid hydrogel with a heterogeneous double network formed by orthogonal assembly. ACS Biomater. Sci. Eng. 2022, 8, 89–99. [Google Scholar] [CrossRef] [PubMed]
- Cai, L.; Liu, S.; Guo, J.; Jia, Y.G. Polypeptide-based self-healing hydrogels: Design and biomedical applications. Acta Biomater. 2020, 113, 84–100. [Google Scholar] [CrossRef] [PubMed]
- Chakraborty, P.; Gazit, E. Amino acid based self-assembled nanostructures: Complex structures from remarkably simple building blocks. ChemNanoMat 2018, 4, 730–740. [Google Scholar] [CrossRef] [PubMed]
- Chang, H.-W.; Lin, Y.-S.; Tsai, Y.-D.; Tsai, M.-L. Effects of chitosan characteristics on the physicochemical properties, antibacterial activity, and cytotoxicity of chitosan/2-glycerophosphate/nanosilver hydrogels. J. Appl. Polym. Sci. 2013, 127, 169–176. [Google Scholar] [CrossRef]
- Das, R.; Gayakvad, B.; Shinde, S.D.; Rani, J.; Jain, A.; Sahu, B. Ultrashort peptides-A glimpse into the structural modifications and their applications as biomaterials. ACS Appl. Bio Mater. 2020, 3, 5474–5499. [Google Scholar] [CrossRef]
- Fichman, G.; Gazit, E. Self-assembly of short peptides to form hydrogels: Design of building blocks, physical properties and technological applications. Acta Biomater. 2014, 10, 1671–1682. [Google Scholar] [CrossRef]
- Frkanec, L.; Zinic, M. Chiral bis(amino acid)-and bis(amino alcohol)-oxalamide gelators. Gelation properties, self-assembly motifs and chirality effects. Chem. Commun. 2010, 46, 522–537. [Google Scholar] [CrossRef]
- Kong, Q.; Yang, Y. Recent advances in antibacterial agents. Bioorg. Med. Chem. Lett. 2021, 35, 127799. [Google Scholar] [CrossRef]
- Szczesna, W.; Tsirigotis-Maniecka, M.; Lamch, L.; Szyk-Warszynska, L.; Zboinska, E.; Warszynski, P.; Wilk, K.A. Multilayered curcumin-loaded hydrogel microcarriers with antimicrobial function. Molecules 2022, 27, 1415. [Google Scholar] [CrossRef] [PubMed]
- Tsai, C.W.; Ruaan, R.C.; Liu, C.I. Adsorption of antimicrobial indolicidin-derived peptides on hydrophobic surfaces. Langmuir 2012, 28, 10446–10452. [Google Scholar] [CrossRef] [PubMed]
- Wongniramaikul, W.; Kleangklao, B.; Boonkanon, C.; Taweekarn, T.; Phatthanawiwat, K.; Sriprom, W.; Limsakul, W.; Towanlong, W.; Tipmanee, D.; Choodum, A. Portable colorimetric hydrogel test kits and on-mobile digital image colorimetry for on-site determination of nutrients in water. Molecules 2022, 27, 7287. [Google Scholar] [CrossRef] [PubMed]
- Dou, X.Q.; Feng, C.L. Amino acids and peptide-based supramolecular hydrogels for three-dimensional cell culture. Adv. Mater. 2017, 29, 1604062. [Google Scholar] [CrossRef]
- Hanula, M.; Szpicer, A.; Gorska-Horczyczak, E.; Khachatryan, G.; Pogorzelski, G.; Pogorzelska-Nowicka, E.; Poltorak, A. Hydrogel emulsion with encapsulated safflower oil enriched with acai extract as a novel fat substitute in beef burgers subjected to storage in cold conditions. Molecules 2022, 27, 2397. [Google Scholar] [CrossRef]
- Kono, H.; Noda, J.; Wakamori, H. Detailed structural characterization of oxidized sucrose and its application in the fully carbohydrate-based preparation of a hydrogel from carboxymethyl chitosan. Molecules 2022, 27, 6137. [Google Scholar] [CrossRef]
- Li, S.; Dong, S.; Xu, W.; Tu, S.; Yan, L.; Zhao, C.; Ding, J.; Chen, X. Antibacterial hydrogels. Adv. Sci. 2018, 5, 1700527. [Google Scholar] [CrossRef]
- Ni, M.; Zhuo, S. Applications of self-assembling ultrashort peptides in bionanotechnology. RSC Adv. 2019, 9, 844–852. [Google Scholar] [CrossRef]
- Singh, P.; Brar, S.K.; Bajaj, M.; Narang, N.; Mithu, V.S.; Katare, O.P.; Wangoo, N.; Sharma, R.K. Self-assembly of aromatic alpha-amino acids into amyloid inspired nano/micro scaled architects. Mater. Sci. Eng. C Mater. Biol. Appl. 2017, 72, 590–600. [Google Scholar] [CrossRef]
- Postolovic, K.S.; Antonijevic, M.D.; Ljujic, B.; Miletic Kovacevic, M.; Gazdic Jankovic, M.; Stanic, Z.D. pH-responsive hydrogel beads based on alginate, kappa-carrageenan and poloxamer for enhanced curcumin, Natural Bioactive Compound, Encapsulation and Controlled Release Efficiency. Molecules 2022, 27, 4045. [Google Scholar] [CrossRef]
- Wu, H.; Zheng, J.; Kjoniksen, A.L.; Wang, W.; Zhang, Y.; Ma, J. Metallogels: Availability, applicability, and advanceability. Adv. Mater. 2019, 31, e1806204. [Google Scholar] [CrossRef] [PubMed]
- Arias, M.; Nguyen, L.T.; Kuczynski, A.M.; Lejon, T.; Vogel, H.J. Position-dependent influence of the three trp residues on the membrane activity of the antimicrobial peptide, tritrpticin. Antibiotics 2014, 3, 595–616. [Google Scholar] [CrossRef] [PubMed]
- Yang, S.T.; Yub Shin, S.Y.; Kim, Y.C.; Kim, Y.; Hahm, K.S.; Kim, J.I. Conformation-dependent antibiotic activity of tritrpticin, a cathelicidin-derived antimicrobial peptide. Biochem. Biophys. Res. Commun. 2002, 296, 1044–1050. [Google Scholar] [CrossRef] [PubMed]
- Song, X.; Zheng, J.; He, S.; Liu, Y.; Yang, S.; Li, Q.; Liu, C.; Zhang, Z.; Liu, X.; Deng, C.; et al. Build in seconds: Small-molecule hydrogels of self-assembled tryptophan derivatives. Chin. Chem. Lett. 2022, 108069. [Google Scholar] [CrossRef]
- Chen, J.; Zhang, S.; Chen, X.; Wang, L.; Yang, W. A Self-assembled fmoc-diphenylalanine hydrogel-encapsulated pt nanozyme as oxidase- and peroxidase-like breaking ph limitation for potential antimicrobial application. Chemistry 2022, 28, e202104247. [Google Scholar] [CrossRef]
- Li, H.; Li, Y.; Wang, Y.; Liu, L.; Dong, H.; Satoh, T. Membrane-active amino acid-coupled polyetheramine derivatives with high selectivity and broad-spectrum antibacterial activity. Acta Biomater. 2022, 142, 136–148. [Google Scholar] [CrossRef]
- Zhang, H.; He, J.; Peng, T.; Qu, J. Ultra-stretchable, antifatigue, adhesive, and self-healing hydrogels based on the amino acid derivative and ionic liquid for flexible strain sensors. ACS Appl. Polym. Mater. 2022, 4, 7575–7586. [Google Scholar] [CrossRef]
- Adams, D.J.; Butler, M.F.; Frith, W.J.; Kirkland, M.; Mullen, L.; Sanderson, P. A new method for maintaining homogeneity during liquid–hydrogel transitions using low molecular weight hydrogelators. Soft. Matter. 2009, 5, 1856. [Google Scholar] [CrossRef]
- Zhao, Y.; Liu, Q.; Zhang, S.; Jiang, L.; Liu, Y.; Han, C. Formation and properties of recombined soymilk and cow’s milk gels: Effect of glucono-delta-lactone. J. Oleo Sci. 2018, 67, 885–892. [Google Scholar] [CrossRef]
- McFetridge, M.L.; Kulkarni, K.; Hilsenstein, V.; Del Borgo, M.P.; Aguilar, M.I.; Ricardo, S.D. A comparison of fixation methods for SEM analysis of self-assembling peptide hydrogel nanoarchitecture. Nanoscale 2023, 15, 1431–1440. [Google Scholar] [CrossRef]
- Cox, A.J. Effect of a hydrogel coating on the surface topography of latex-based urinary catheters: An SEM study. Biomaterials 1987, 8, 500–502. [Google Scholar] [CrossRef] [PubMed]
- Song, X.W.; He, T.; Qi, Y.J.; Liu, Y.L.; Wu, H.Q.; Liu, C.T.; Zhang, Y. Properties of cell-compatible poly(vinyl alcohol) hydrogels cross-linked with hydrophobic luteolin. ACS Appl. Polym. Mater. 2021, 3, 3019–3027. [Google Scholar] [CrossRef]
- Wu, S.; Hua, M.; Alsaid, Y.; Du, Y.; Ma, Y.; Zhao, Y.; Lo, C.Y.; Wang, C.; Wu, D.; Yao, B.; et al. Poly(vinyl alcohol) hydrogels with broad-range tunable mechanical properties via the hofmeister effect. Adv. Mater. 2021, 33, e2007829. [Google Scholar] [CrossRef] [PubMed]
- Song, X.; Zhang, Z.; Shen, Z.; Zheng, J.; Liu, X.; Ni, Y.; Quan, J.; Li, X.; Hu, G.; Zhang, Y. Facile preparation of drug-releasing supramolecular hydrogel for preventing postoperative peritoneal adhesion. ACS Appl. Mater. Interfaces 2021, 13, 56881–56891. [Google Scholar] [CrossRef] [PubMed]
- Yuan, C.; Levin, A.; Chen, W.; Xing, R.; Zou, Q.; Herling, T.W.; Challa, P.K.; Knowles, T.P.J.; Yan, X. Nucleation and growth of amino acid and peptide supramolecular polymers through liquid-liquid phase separation. Angew. Chem. Int. Ed. Engl. 2019, 58, 18116–18123. [Google Scholar] [CrossRef] [PubMed]
- Jie, K.; Zhou, Y.; Shi, B.; Yao, Y. A Cu2+ specific metallohydrogel: Preparation, multi-responsiveness and pillar[5]arene-induced morphology transformation. Chem. Commun. 2015, 51, 8461–8464. [Google Scholar] [CrossRef] [PubMed]
- Shaller, A.D.; Wang, W.; Gan, H.; Li, A.D. Tunable molecular assembly codes direct reaction pathways. Angew. Chem. Int. Ed. Engl. 2008, 47, 7705–7709. [Google Scholar] [CrossRef]
- Wang, F.; Ji, W.; Yang, P.; Feng, C.-L. Inversion of circularly polarized luminescence of nanofibrous hydrogels through co-assembly with achiral coumarin derivatives. ACS Nano 2019, 13, 7281–7290. [Google Scholar] [CrossRef]
- Ceruso, M.; Howe, N.; Malthouse, J.P.G. Mechanism of the binding of Z–L-tryptophan and Z–L-phenylalanine to thermolysin and stromelysin-1 in aqueous solutions. Biochim. Biophys. Acta BBA-Proteins Proteom. 2012, 1824, 303–310. [Google Scholar] [CrossRef]
- Rodríguez-Llansola, F.; Hermida-Merino, D.; Nieto-Ortega, B.; Ramírez, F.J.; Navarrete, J.T.L.; Casado, J.; Hamley, I.W.; Escuder, B.; Hayes, W.; Miravet, J.F. Self-assembly studies of a chiral bisurea-based superhydrogelator. Chem.-A Eur. J. 2012, 18, 14725–14731. [Google Scholar] [CrossRef]
- Bera, S.; Mondal, S.; Xue, B.; Shimon, L.J.W.; Cao, Y.; Gazit, E. Rigid helical-like assemblies from a self-aggregating tripeptide. Nat. Mater. 2019, 18, 503–509. [Google Scholar] [CrossRef] [PubMed]
- Li, J.; Kuang, Y.; Gao, Y.; Du, X.; Shi, J.; Xu, B. D-amino acids boost the selectivity and confer supramolecular hydrogels of a nonsteroidal anti-inflammatory drug (NSAID). J. Am. Chem. Soc. 2013, 135, 542–545. [Google Scholar] [CrossRef] [PubMed]
- Fu, P.S.; Wang, J.C.; Lai, P.L.; Liu, S.M.; Chen, Y.S.; Chen, W.C.; Hung, C.C. Effects of gamma radiation on the sterility assurance, antibacterial ability, and biocompatibility of impregnated hydrogel macrosphere protein and drug release. Polymers 2021, 13, 938. [Google Scholar] [CrossRef]
- Jeong, H.I.; An, D.H.; Lim, J.W.; Oh, T.; Lee, H.; Park, S.M.; Jeong, J.H.; Chung, J.W. Hydrogel surface-modified polyurethane copolymer film with water permeation resistance and biocompatibility for implantable biomedical devices. Micromachines 2021, 12, 447. [Google Scholar] [CrossRef] [PubMed]
- Sobierajska, P.; Nowak, N.; Rewak-Soroczynska, J.; Targonska, S.; Lewinska, A.; Grosman, L.; Wiglusz, R.J. Investigation of topography effect on antibacterial properties and biocompatibility of nanohydroxyapatites activated with zinc and copper ions: In vitro study of colloids, hydrogel scaffolds and pellets. Biomater. Adv. 2022, 134, 112547. [Google Scholar] [CrossRef]
- Suzuki, M.; Hanabusa, K. L-lysine-based low-molecular-weight gelators. Chem. Soc. Rev. 2009, 38, 967–975. [Google Scholar] [CrossRef]
- Suzuki, M.; Yumoto, M.; Shirai, H.; Hanabusa, K. Supramolecular gels formed by amphiphilic low-molecular-weight gelators of N alpha,N epsilon-diacyl-L-lysine derivatives. Chemistry 2008, 14, 2133–2144. [Google Scholar] [CrossRef]
- Tian, M.; Zhou, L.; Fan, C.; Wang, L.; Lin, X.; Wen, Y.; Su, L.; Dong, H. Bimetal-organic framework/GOx-based hydrogel dressings with antibacterial and inflammatory modulation for wound healing. Acta Biomater. 2022, 158, 252–265. [Google Scholar] [CrossRef]
- Kim, S.Y.; Choi, A.J.; Park, J.E.; Jang, Y.S.; Lee, M.H. Antibacterial activity and biocompatibility with the concentration of ginger fraction in biodegradable gelatin methacryloyl (GelMA) hydrogel coating for medical implants. Polymers 2022, 14, 5317. [Google Scholar] [CrossRef]
- Wang, Z.; Lu, J.; Yuan, Z.; Pi, W.; Huang, X.; Lin, X.; Zhang, Y.; Lei, H.; Wang, P. Natural carrier-free binary small molecule self-assembled hydrogel synergize antibacterial effects and promote wound healing by inhibiting virulence factors and alleviating the inflammatory response. Small 2023, 19, e2205528. [Google Scholar] [CrossRef]

Disclaimer/Publisher’s Note: The statements, opinions and data contained in all publications are solely those of the individual author(s) and contributor(s) and not of MDPI and/or the editor(s). MDPI and/or the editor(s) disclaim responsibility for any injury to people or property resulting from any ideas, methods, instructions or products referred to in the content. |
© 2023 by the authors. Licensee MDPI, Basel, Switzerland. This article is an open access article distributed under the terms and conditions of the Creative Commons Attribution (CC BY) license (https://creativecommons.org/licenses/by/4.0/).
Share and Cite
Song, X.; He, S.; Zheng, J.; Yang, S.; Li, Q.; Zhang, Y. One-Step Construction of Tryptophan-Derived Small Molecule Hydrogels for Antibacterial Materials. Molecules 2023, 28, 3334. https://doi.org/10.3390/molecules28083334
Song X, He S, Zheng J, Yang S, Li Q, Zhang Y. One-Step Construction of Tryptophan-Derived Small Molecule Hydrogels for Antibacterial Materials. Molecules. 2023; 28(8):3334. https://doi.org/10.3390/molecules28083334
Chicago/Turabian StyleSong, Xianwen, Shunmei He, Jun Zheng, Shutong Yang, Qiang Li, and Yi Zhang. 2023. "One-Step Construction of Tryptophan-Derived Small Molecule Hydrogels for Antibacterial Materials" Molecules 28, no. 8: 3334. https://doi.org/10.3390/molecules28083334
APA StyleSong, X., He, S., Zheng, J., Yang, S., Li, Q., & Zhang, Y. (2023). One-Step Construction of Tryptophan-Derived Small Molecule Hydrogels for Antibacterial Materials. Molecules, 28(8), 3334. https://doi.org/10.3390/molecules28083334
